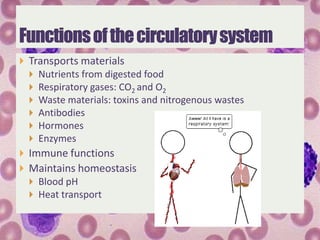
 Transports materials
     Nutrients from digested food
     Respiratory gases: CO2 and O2
     Waste materials: toxins and nitrogenous wastes
     Antibodies
     Hormones
     Enzymes
 Immune functions
 Maintains homeostasis
   Blood pH
   Heat transport

The circulatory system transports nutrients, gases, wastes, antibodies, hormones and enzymes throughout the body. Invertebrates use diffusion, gastrovascular cavities or open circulatory systems. Vertebrates have closed circulatory systems with hearts and blood vessels. Fish have single circulation hearts while amphibians, reptiles, birds and mammals have increasingly divided multi-chambered hearts to separate oxygenated and deoxygenated blood.